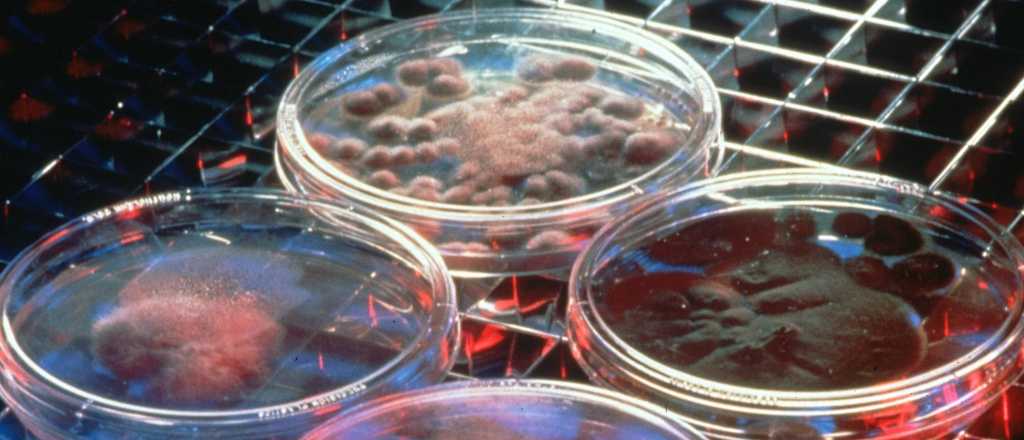
Una experiencia y claves sobre el origen de la vida

Los seres vivos pudieron surgir de una sopa química primigenia en la que las moléculas se replicaron y organizaron de forma autónoma, según un estudio que publicó la revista Nature Chemistry.
Científicos de los Países Bajos han profundizado en el conocimiento de un tipo de molécula que puede replicarse a sí misma y han comprobado que ese proceso genera nuevas "ramas" de moléculas, un desarrollo en el que observan similitudes con la evolución biológica.
El investigador de la Universidad de Groninga Sijbren Otto y su grupo identificaron hace años un péptido -un tipo de molécula formada por la unión de aminoácidos- que tiende a organizarse en anillos, que a su vez se apilan para formar estructuras más complejas.
Esas pilas de anillos eventualmente se rompen, dando lugar a dos estructuras similares que se continúan replicando.
El estudio publicado ahora en Nature Chemistry constata cómo ese proceso controlado dio lugar en el laboratorio a una nueva clase de anillos con características distintas a las iniciales.
"Ese segundo grupo (de anillos) era descendiente del primero", señalan los investigadores en un comunicado divulgado por su universidad, en el que subrayan que "ese proceso es muy similar a cómo se forman las nuevas especies a partir otras existentes en la evolución biológica".
"La vida debió comenzar en algún punto, pero cómo se produjo ese salto continúa siendo un misterio", señala el grupo de investigadores.
La creación de seres vivos a partir de materia inerte debió de involucrar procesos de "autocatálisis", en los que las moléculas crean copias de sí mismas, y de "autoorganización", en los que se crean estructuras más complejas de manera espontánea, según los científicos.
El grupo de Otto considera que su experimento muestra que "nuevas especies pueden emerger a partir de la evolución química".
Según los investigadores, su trabajo con moléculas simples replica "los mismos patrones" que se observan en "organismos que se reproducen de forma sexual".
Ver también: Los mejores descubrimientos científicos de 2015